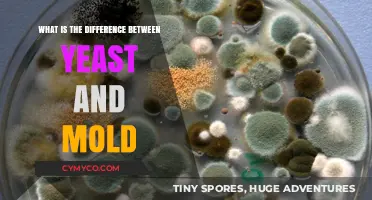
Yeast vs. Mold: Understanding the Key Differences and Uses

Fungi are a unique group of organisms that play a crucial role in ecosystems, but their classification as producers, consumers, or decomposers is not straightforward. Unlike plants, fungi do not produce their own food through photosynthesis, ruling them out as primary producers. However, they also do not consume living organisms directly like typical consumers. Instead, fungi primarily act as decomposers, breaking down dead organic matter such as plants, animals, and waste materials, recycling nutrients back into the ecosystem. Some fungi, like certain species of mushrooms, form symbiotic relationships with plants (mycorrhizae) or algae (lichens), where they exchange nutrients, blurring the lines between their roles. Thus, while fungi are predominantly decomposers, their diverse lifestyles make them a fascinating and complex group in ecological terms.
Explore related products
What You'll Learn
- Fungi as Decomposers: Breaking down organic matter, recycling nutrients in ecosystems
- Fungi as Symbionts: Mutualistic relationships with plants, aiding nutrient absorption
- Fungi as Parasites: Consuming living hosts, causing harm to organisms
- Fungi as Saprotrophs: Feeding on dead organisms, decomposing complex materials
- Fungi as Producers: Some fungi perform photosynthesis via algal partnerships (lichens)

Fungi as Decomposers: Breaking down organic matter, recycling nutrients in ecosystems
Fungi are nature’s recyclers, breaking down dead organic matter into simpler compounds that can re-enter the ecosystem. Unlike producers, which create energy through photosynthesis, or consumers, which feed on other organisms, fungi specialize in decomposition. This process is driven by their unique ability to secrete enzymes that dissolve complex materials like lignin and cellulose, found in wood and plant debris. Without fungi, forests would be buried under layers of undecomposed material, and essential nutrients like nitrogen and phosphorus would remain locked away, starving other organisms.
Consider the forest floor, where fallen leaves and dead trees accumulate. Fungi, such as mushrooms and molds, colonize these substrates, releasing enzymes that break down tough plant fibers. As they grow, they absorb nutrients from the decaying matter, then release these nutrients back into the soil when their own tissues decompose. This recycling process is critical for soil fertility, enabling plants to access the nutrients they need to grow. For example, mycorrhizal fungi form symbiotic relationships with plant roots, enhancing nutrient uptake in exchange for carbohydrates produced by the plant.
To understand the scale of fungal decomposition, imagine a single cubic meter of forest soil, which can contain kilometers of fungal hyphae—the thread-like structures fungi use to explore and break down organic matter. These hyphae act like microscopic conveyor belts, transporting nutrients from decaying material to living plants and microorganisms. In agricultural systems, farmers can harness this process by incorporating fungal-rich compost into soil, improving structure and nutrient availability. For home gardeners, adding mushroom compost or allowing natural fungal growth in mulch can enhance plant health without synthetic fertilizers.
However, fungal decomposition is not without challenges. Environmental factors like temperature, moisture, and pH influence fungal activity. For instance, fungi thrive in moist, cool conditions, which is why decomposition slows in arid or extremely hot environments. Additionally, certain pollutants can inhibit fungal growth, disrupting nutrient cycling. To optimize fungal decomposition in managed ecosystems, maintain soil moisture through mulching, avoid chemical overuse, and incorporate organic matter regularly.
In conclusion, fungi are indispensable decomposers, driving the nutrient cycle that sustains life on Earth. Their ability to break down complex organic matter and recycle nutrients highlights their ecological importance. By understanding and supporting fungal activity, we can improve soil health, enhance biodiversity, and promote sustainable ecosystems. Whether in a forest, farm, or garden, fungi remind us that even in death, life finds a way to persist and thrive.
Exploring Fungi Habitats: Where These Unique Organisms Thrive in Nature
You may want to see also
Explore related products
$9.99

Fungi as Symbionts: Mutualistic relationships with plants, aiding nutrient absorption
Fungi, often categorized as decomposers due to their role in breaking down organic matter, also thrive as symbionts in mutualistic relationships with plants. One of the most well-known examples is the mycorrhizal association, where fungal hyphae extend the root systems of plants, significantly enhancing nutrient absorption. This partnership is particularly crucial for plants in nutrient-poor soils, where fungi unlock phosphorus, nitrogen, and micronutrients that would otherwise remain inaccessible. In return, the plant provides carbohydrates produced through photosynthesis, creating a balanced exchange that benefits both organisms.
Consider the steps involved in establishing this symbiotic relationship. First, fungal spores germinate in the soil near plant roots. Next, the hyphae penetrate the root cells without causing harm, forming a network that interfaces with the plant’s tissues. This process requires specific compatibility between the plant and fungal species, as not all combinations result in mutualism. Gardeners and farmers can encourage mycorrhizal growth by minimizing soil disturbance, avoiding excessive phosphorus fertilization, and using fungal inoculants when planting crops like tomatoes, wheat, or trees. Caution should be taken to avoid fungicides that disrupt these beneficial fungi, as their loss can reduce plant health and yield.
Analyzing the impact of this relationship reveals its ecological and agricultural significance. Mycorrhizal fungi can increase a plant’s nutrient uptake efficiency by up to 100-fold, particularly in challenging environments like arid or polluted soils. For instance, pine trees in nutrient-poor forests rely heavily on ectomycorrhizal fungi to survive. In agriculture, mycorrhizal inoculation has been shown to reduce fertilizer needs by 20-50%, offering a sustainable solution to nutrient management. However, the effectiveness of this symbiosis depends on factors like soil pH, moisture, and temperature, highlighting the need for tailored approaches in different settings.
Persuasively, adopting practices that support mycorrhizal fungi is not just beneficial—it’s essential for sustainable agriculture and ecosystem restoration. By fostering these relationships, we can improve soil health, enhance crop resilience, and reduce environmental impact. For example, integrating cover crops like clover or alfalfa can promote fungal growth, while reducing tillage preserves existing networks. Even in urban gardening, using compost rich in fungal activity can boost plant vitality. The takeaway is clear: viewing fungi as partners rather than passive decomposers unlocks their full potential in supporting plant life.
Descriptively, imagine a forest floor teeming with life, where delicate fungal networks weave through the soil, connecting trees in a hidden web of mutual support. These mycorrhizal fungi act as the internet of the plant world, facilitating nutrient exchange and even warning plants of pathogens. In agricultural fields, this underground alliance translates to healthier crops, reduced erosion, and improved water retention. By nurturing these relationships, we not only optimize plant growth but also contribute to a more resilient and biodiverse environment. Practical tips include testing soil health annually, avoiding chemical overuse, and selecting plant species known to thrive with specific fungal partners.
Adding Mycorrhizal Fungi Post-Planting: Benefits and Best Practices
You may want to see also
Explore related products

Fungi as Parasites: Consuming living hosts, causing harm to organisms
Fungi, often categorized as decomposers, reveal a darker side when they adopt a parasitic lifestyle. Unlike their saprotrophic counterparts that feed on dead organic matter, parasitic fungi target living hosts, extracting nutrients at the host's expense. This relationship is inherently harmful, as the fungus invades tissues, disrupts physiological processes, and often leads to disease or death in the host organism. Examples range from plant pathogens like *Fusarium* and *Phytophthora* to human infections caused by *Candida* and *Aspergillus*. Understanding this parasitic behavior is crucial, as it highlights fungi's adaptability and their significant impact on ecosystems, agriculture, and human health.
Consider the life cycle of a parasitic fungus, which begins with spore germination on or within a susceptible host. Once established, the fungus penetrates host cells using specialized structures like appressoria or haustoria, secreting enzymes to break down cell walls and absorb nutrients. This process is not merely feeding—it’s an invasion that weakens the host. For instance, *Magnaporthe oryzae*, the rice blast fungus, can destroy up to 30% of a rice crop annually, demonstrating the economic and ecological consequences of such parasitism. Farmers combat this by applying fungicides like tricyclazole at a rate of 0.5–1.0 kg per hectare, but resistance is a growing concern.
From a comparative perspective, parasitic fungi differ from other parasites like bacteria or viruses in their mode of action. While bacteria often rely on rapid replication and toxin production, fungi excel at long-term colonization, forming extensive networks (mycelia) within host tissues. This persistence allows them to exploit hosts over extended periods, sometimes leading to chronic infections. For example, *Cryptococcus neoformans* can cause life-threatening meningitis in immunocompromised individuals, requiring antifungal treatments like amphotericin B (0.7–1.0 mg/kg/day) for weeks. The ability of fungi to adapt to host defenses, such as by altering cell wall composition, underscores their evolutionary sophistication as parasites.
To mitigate the harm caused by parasitic fungi, proactive measures are essential. In agriculture, crop rotation, resistant varieties, and biological control agents like *Trichoderma* can reduce fungal infections. For human health, early diagnosis and targeted therapy are critical. For instance, *Candida auris*, a multidrug-resistant fungus, requires combination therapy with echinocandins and azoles. Practical tips include maintaining hygiene in healthcare settings, monitoring indoor humidity to prevent mold growth, and using fungicides judiciously to avoid resistance. By recognizing fungi's parasitic potential, we can better protect both ecosystems and human well-being.
In conclusion, fungi's role as parasites challenges their simplistic classification as decomposers. Their ability to consume living hosts, coupled with their adaptive strategies, makes them formidable organisms with far-reaching impacts. Whether in fields, forests, or hospitals, understanding and managing parasitic fungi requires a nuanced approach that balances ecological dynamics with practical interventions. This knowledge not only deepens our appreciation of fungal biology but also equips us to address the challenges they pose.
Effective Ways to Eliminate Birds Nest Fungi from Your Garden
You may want to see also
Explore related products

Fungi as Saprotrophs: Feeding on dead organisms, decomposing complex materials
Fungi, often overshadowed by their more visible counterparts in the natural world, play a pivotal role as saprotrophs, organisms that derive nutrients from dead and decaying organic matter. Unlike producers, which create their own food through photosynthesis, or consumers, which feed on living organisms, saprotrophic fungi specialize in breaking down complex materials such as cellulose, lignin, and chitin. This process not only recycles nutrients back into ecosystems but also ensures the continuity of life by decomposing what would otherwise accumulate as waste.
Consider the forest floor, where fallen leaves, dead trees, and animal remains accumulate. Saprotrophic fungi, such as *Aspergillus* and *Penicillium*, secrete enzymes that degrade these materials into simpler compounds. These fungi absorb the resulting nutrients, effectively converting organic debris into forms usable by other organisms. For instance, cellulose, a structural component of plant cell walls that most animals cannot digest, is broken down by fungal enzymes like cellulases. This ability makes fungi indispensable in nutrient cycling, particularly in ecosystems where decomposition is critical for soil fertility.
The process of decomposition by saprotrophic fungi is not merely mechanical but a sophisticated biochemical operation. Fungi secrete a suite of enzymes tailored to the material they encounter. Lignin, a tough polymer in wood, is degraded by lignin peroxidases and laccases, while proteins are broken down by proteases. This enzymatic arsenal allows fungi to access nutrients locked within complex structures, a capability that few other organisms possess. Practical applications of this process are seen in industries like biofuel production, where fungal enzymes are used to convert plant biomass into usable energy.
However, the role of saprotrophic fungi extends beyond ecosystems and industries. In agriculture, these fungi improve soil health by decomposing crop residues, enhancing nutrient availability for plants. Gardeners can encourage saprotrophic activity by adding organic matter like compost, which provides a substrate for fungal growth. Additionally, certain saprotrophic fungi, such as *Trichoderma*, are used as biocontrol agents to suppress plant pathogens. For optimal results, incorporate compost rich in diverse organic materials and maintain soil moisture, as fungal activity is water-dependent.
In conclusion, saprotrophic fungi are unsung heroes of decomposition, bridging the gap between death and renewal in ecosystems. Their ability to break down complex materials not only sustains life but also offers practical solutions in agriculture and industry. By understanding and supporting their role, we can harness their potential to address challenges from waste management to sustainable resource use. Whether in a forest, garden, or lab, these fungi remind us of the intricate balance between decay and growth.
Exploring Fungi Habitats: Where These Diverse Organisms Thrive and Survive
You may want to see also
Explore related products

Fungi as Producers: Some fungi perform photosynthesis via algal partnerships (lichens)
Fungi are often pigeonholed as decomposers, breaking down dead organic matter. Yet, a fascinating exception exists: lichens. These composite organisms are a symbiotic partnership between fungi and algae, where the fungus provides structure and protection, and the alga performs photosynthesis, producing nutrients for both. This unique collaboration challenges the traditional view of fungi as purely heterotrophic, revealing a hidden role as producers in certain ecosystems.
Consider the harsh environments where lichens thrive: barren rocks, Arctic tundra, and desert surfaces. In these nutrient-poor habitats, lichens are often the primary producers, creating organic matter where few other organisms can survive. The fungus, typically an ascomycete or basidiomycete, forms a protective thallus that shelters the alga, often a green alga or cyanobacterium. In return, the alga provides carbohydrates synthesized through photosynthesis, sustaining both partners. This mutualistic relationship showcases the adaptability and ecological significance of fungi, highlighting their ability to contribute to primary production under extreme conditions.
To understand this process, imagine a lichen as a tiny, self-sustaining ecosystem. The fungal partner, or mycobiont, secretes acids that break down rock surfaces, releasing minerals essential for algal growth. The algal partner, or photobiont, uses sunlight to convert carbon dioxide and water into glucose, fueling both organisms. This efficient division of labor allows lichens to colonize environments where plants cannot, making them pioneers in ecological succession. For instance, lichens are often the first organisms to grow on bare rock after a volcanic eruption, gradually breaking down the substrate and preparing the way for more complex plant life.
Practical observations of lichens can deepen appreciation for their role as producers. Look for them on tree bark, boulders, or even soil crusts in arid regions. Their diverse forms—from leafy and bushy to crust-like and filamentous—reflect adaptations to different environments. To study lichens up close, collect a small sample (ethically, avoiding over-harvesting) and examine it under a magnifying glass or microscope. Notice the layered structure: the upper cortex, algal layer, medulla, and lower cortex. This intricate design optimizes photosynthesis while protecting the alga from desiccation and UV radiation.
In conclusion, lichens redefine the role of fungi in ecosystems, demonstrating their capacity to act as producers through algal partnerships. This symbiotic relationship not only sustains life in extreme habitats but also contributes to nutrient cycling and soil formation. By studying lichens, we gain insight into the versatility of fungi and their indispensable role in the web of life. Next time you encounter a lichen, remember: it’s not just a fungus—it’s a miniature ecosystem, a testament to the power of cooperation in nature.
Unveiling the Fungal Mystery: Identifying Milady's Unique Fungus Type
You may want to see also
Frequently asked questions
A fungus is primarily a decomposer. It breaks down dead organic matter, such as plants and animals, into simpler substances, recycling nutrients back into the ecosystem.
Fungi are not producers because they cannot perform photosynthesis. However, some fungi act as consumers in symbiotic relationships, such as mycorrhizal fungi that exchange nutrients with plants, or parasitic fungi that obtain nutrients from living hosts.
Fungi are essential decomposers because they secrete enzymes to break down complex organic materials like lignin and cellulose, which many other organisms cannot digest. This process releases nutrients that support plant growth and maintain soil health.